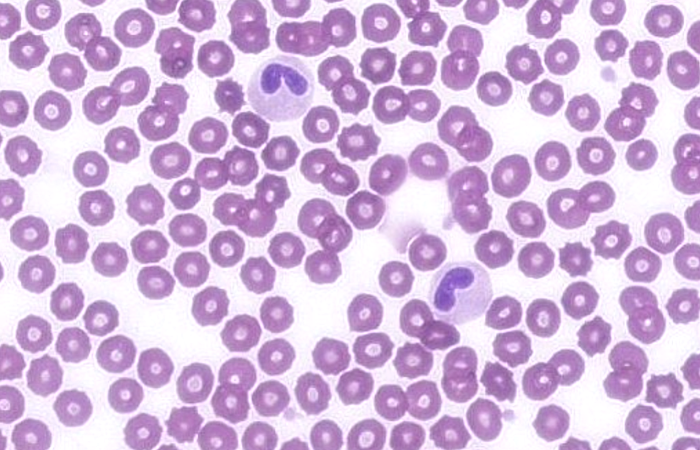

Cytology Reading Sessions ‘Haematology 5.0’ (19/03/26)
Member exclusive
Our cytology reading sessions are a great way for our Specialists to bring interesting cases for discussion with our vtx community. In this session, the theme of the cytology reading session is haematology.
Meet the speakers

Francesco Cian
Clinical pathology Specialist
Francesco Cian graduated in Veterinary Medicine from the University of Padua, Italy, in 2006. After several years as a general practitioner, he relocated to the UK in 2010 to pursue a residency in Veterinary Clinical Pathology at the University of Cambridge, completing it in 2013 with both ECVCP and FRCPath diplomas. He became Head of Veterinary Clinical Pathology at the Animal Health Trust in late 2013 and joined BattLab (LABOKLIN) as a Senior Veterinary Clinical Pathologist in 2015. Dr. Cian also freelances for digital cytology laboratories. In 2024, he was honoured with a Fellowship from the RCVS for his contributions to clinical practice. Currently, he serves as the Secretary of the ECVCP and is a member of the Cytology Examination Board. Dr. Cian has authored several peer-reviewed publications, edited three cytology books, and co-authored the cytology chapter in the BSAVA Manual of Veterinary Clinical Pathology. He is actively involved in veterinary education, speaking and organizing courses for several education providers. Dr. Cian is also actively involved in providing education via social media and has a specialized website dedicated to veterinary cytology.
already a member? login to your vtx account for access
get membership
check out all our other webinars webinars